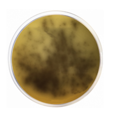
E-shop hlavní obrázek

Žluč eskulin agar (B.E.A.) agar je médium pro izolaci a diferenciaci streptokoku skupiny D podle Lancefieldové.
Kultivační půda určená pro izolaci a předběžnou identifikaci enterokoků a pro studování fermentace eskulinu rodem Yersinia podle ISO 10273 (rovnocenný testu na fermentaci salicinu).
Produkt je dodáván v dehydratované formě a je určen pro přípravu hotových kultivačních médií.

Selektivní médium pro obohacení Salmonella spp. ve vzorcích potravin, vody a stolice.
Tento produkt je dodáván v dehydratované formě a je určen pro přípravu hotových kultivačních médií.

Selektivní médium pro konfirmaci koliformních bakterií ve vodě a potravinách.
Produkt je dodáván v dehydratované formě a je určen pro přípravu hotových kultivačních médií.

CE IVD certifikovaný diagnostický kit pro detekci 22 mutací specifických pro oblast jihovýchodní Asie spojených s beta thalassémií.

CE IVD certifikovaný diagnostický kit pro detekci 5 nejčastějších mutací spojených s Beta thalassémií.